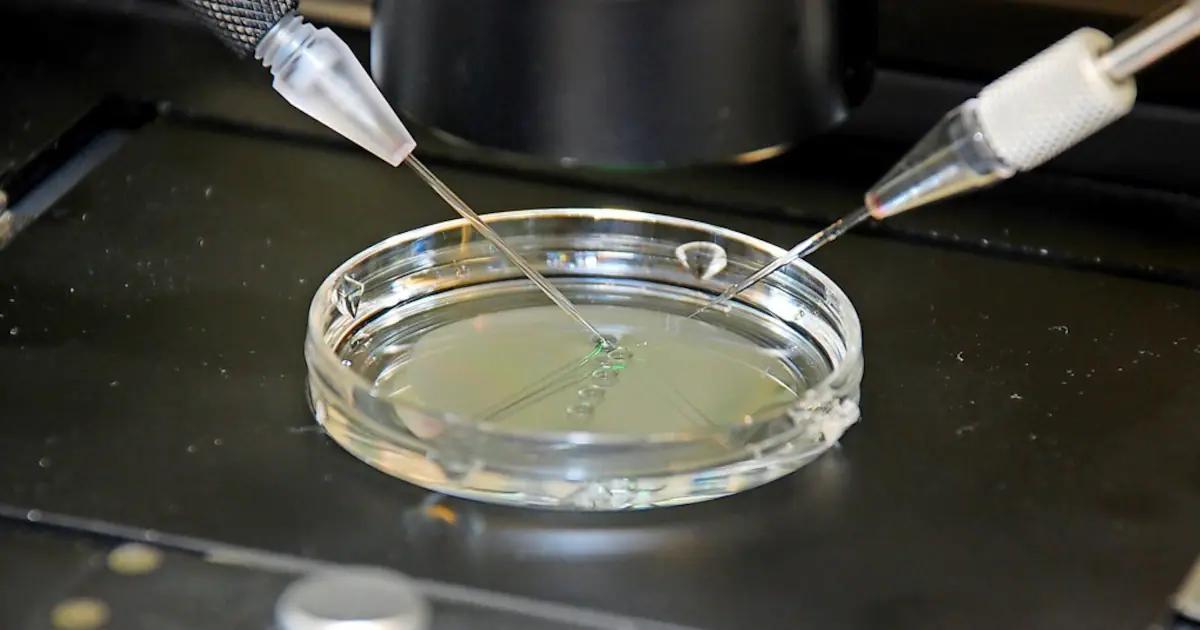
ivf geburt - Wie gesund sind IVF Babys

Die In-vitro-Fertilisation (IVF), auch bekannt als künstliche Befruchtung, ist ein Verfahren, bei dem die Befruchtung einer Eizelle durch ein Spermium außerhalb des Körpers stattfindet. Die befruchtete Eizelle (Embryo) wird dann in die Gebärmutter der Frau übertragen, wo sie sich hoffentlich einnistet und zu einem Baby heranwächst.
IVF ist eine komplexe und zeitaufwendige Behandlung, die viele verschiedene Schritte umfasst. Es ist jedoch eine der effektivsten Behandlungen für Unfruchtbarkeit und hat vielen Paaren geholfen, ihren Traum von einem Kind zu verwirklichen.
- Wie funktioniert IVF?
- Vorteile von IVF
- Risiken und Komplikationen von IVF
- Kosten von IVF
- IVF und die Gesetzgebung in Deutschland
- IVF und die Zukunft
- Häufig gestellte Fragen
- Wie hoch ist die Erfolgsrate von IVF?
- Wie viele IVF-Zyklen sind empfehlenswert?
- Gibt es eine Altersgrenze für IVF?
- Wie lange dauert eine IVF-Behandlung?
- Was sind die Risiken von IVF?
- Wie hoch sind die Kosten für eine IVF-Behandlung?
- Welche Voraussetzungen müssen erfüllt sein, um eine IVF-Behandlung zu erhalten?
- Fazit
Wie funktioniert IVF?
Der IVF-Prozess lässt sich in verschiedene Phasen unterteilen:

Downregulation
Die Downregulation ist der erste Schritt im IVF-Prozess. Hierbei wird die körpereigene Hormonproduktion der Frau unterdrückt, um einen natürlichen Eisprung zu verhindern. Dies geschieht mit Hormonen wie GnRH-Agonisten oder GnRH-Antagonisten.
Stimulation der Eizellreifung
Nach der Downregulation folgt die Stimulation der Eizellreifung. Hierbei bekommt die Frau täglich Hormonpräparate, die die Eierstöcke dazu anregen, mehrere Eizellen gleichzeitig reifen zu lassen. Dies erhöht die Erfolgschancen der IVF-Behandlung.
Kontrolluntersuchungen
Während der Stimulation werden regelmäßig Kontrolluntersuchungen durchgeführt, um die Größe und Reife der Eibläschen zu überprüfen. Dies geschieht durch Ultraschalluntersuchungen und Bluttests.
Einleitung des Eisprungs
Wenn die Eizellen herangereift sind, wird der Eisprung mit einer Hormonspritze (HCG) oder einem GnRH-Agonisten ausgelöst.
Entnahme der Eizellen
Etwa 36 Stunden nach der Einleitung des Eisprungs werden die Eizellen mit einer feinen Nadel aus den Eibläschen entnommen. Dieser Eingriff wird meist durch die Vagina durchgeführt und per Ultraschall überwacht.
Bereitstellung des Spermas
Am Tag der Eizell-Entnahme wird frisches oder tiefgefrorenes Sperma des Partners benötigt. Der Mann kann das Sperma durch Masturbation in einem speziellen Raum des reproduktionsmedizinischen Zentrums gewinnen. Bei Schwierigkeiten mit der Samengewinnung kann eine andere Lösung mit dem Arzt besprochen werden.
Befruchtung im Labor
Die Eizellen werden im Labor mit dem Sperma zusammengebracht. 16 bis 20 Stunden später kann man unter dem Mikroskop erkennen, ob es zu einer Befruchtung gekommen ist. Die befruchteten Eizellen (Embryonen) werden dann in einem Brutschrank weiterentwickelt.
Übertragung der Embryonen
Zwischen dem zweiten bis maximal sechsten Tag nach der Eizell-Entnahme werden ein bis höchstens drei Embryonen in die Gebärmutter der Frau übertragen. Dieser Eingriff geschieht mithilfe eines dünnen, biegsamen Schlauchs (Katheter) durch die Vagina.
Kontrolluntersuchungen
Etwa 14 Tage nach der Embryoübertragung lässt sich anhand des Schwangerschaftshormons HCG im Blut feststellen, ob eine Schwangerschaft begonnen hat. Regelmäßige Kontrolluntersuchungen werden durchgeführt, um den Verlauf der Schwangerschaft zu überwachen.
Vorteile von IVF
IVF bietet viele Vorteile für Paare, die Schwierigkeiten haben, auf natürlichem Weg ein Kind zu bekommen. Hier sind einige der wichtigsten Vorteile:
- Hohe Erfolgsraten: IVF hat eine hohe Erfolgsrate, besonders bei jungen Frauen. Die Erfolgsrate hängt jedoch von verschiedenen Faktoren ab, wie z.B. Dem Alter der Frau, der Ursache der Unfruchtbarkeit und der Anzahl der übertragenen Embryonen.
- Kontrolle über die Befruchtung: IVF ermöglicht es, die Befruchtung der Eizelle im Labor zu kontrollieren. Dies ermöglicht es den Ärzten, die besten Eizellen und Spermien auszuwählen und die Befruchtung unter optimalen Bedingungen durchzuführen.
- Möglichkeit der genetischen Untersuchung: Vor der Embryoübertragung können die Embryonen auf genetische Erkrankungen untersucht werden. Dies ermöglicht es den Eltern, gesunde Embryonen auszuwählen und das Risiko, ein Kind mit einer genetischen Erkrankung zu bekommen, zu verringern.
- Möglichkeit der Einfrierung von Embryonen: Nicht alle Embryonen werden sofort in die Gebärmutter übertragen. Die restlichen Embryonen können eingefroren und für spätere IVF-Behandlungen verwendet werden.
Risiken und Komplikationen von IVF
Wie jede medizinische Behandlung birgt auch IVF gewisse Risiken und Komplikationen. Diese können sowohl die Frau als auch den Embryo betreffen.
- Mehrlingsschwangerschaften: Die Übertragung von mehreren Embryonen erhöht das Risiko einer Mehrlingsschwangerschaft. Mehrlingsschwangerschaften können für die Mutter und die Babys ein erhöhtes Risiko für Komplikationen darstellen.
- Überstimulation der Eierstöcke: Die hormonelle Stimulation der Eierstöcke kann zu einer Überstimulation führen. Dies kann zu Schmerzen, Flüssigkeitsansammlungen im Bauchraum und anderen Komplikationen führen.
- Eileiterschwangerschaft: In seltenen Fällen kann sich ein Embryo außerhalb der Gebärmutter, z.B. In einem Eileiter, einnisten. Dies führt zu einer Eileiterschwangerschaft, die lebensbedrohlich sein kann.
- Fehlgeburt: Die Fehlgeburtsrate bei IVF-Schwangerschaften ist etwas höher als bei natürlichen Schwangerschaften.
- Geburtsfehler: Es gibt einige Hinweise darauf, dass IVF-Kinder ein leicht erhöhtes Risiko für Geburtsfehler haben. Allerdings ist der Zusammenhang zwischen IVF und Geburtsfehlern noch nicht vollständig geklärt.
Kosten von IVF
IVF ist eine teure Behandlung. Die Kosten variieren je nach Klinik, Verfahren und Anzahl der Behandlungszyklen. In Deutschland liegen die Kosten für einen IVF-Zyklus zwischen 000 und 000 Euro. Die Kosten können durch zusätzliche Leistungen wie genetische Untersuchungen oder Einfrierung von Embryonen noch steigen.
IVF und die Gesetzgebung in Deutschland
In Deutschland ist IVF legal und wird von den Krankenkassen unter bestimmten Voraussetzungen bezuschusst. Die gesetzlichen Krankenkassen übernehmen in der Regel die Kosten für maximal drei IVF-Zyklen. Allerdings gibt es einige Einschränkungen, z.B. In Bezug auf das Alter der Frau und die Ursache der Unfruchtbarkeit.
IVF und die Zukunft
IVF ist eine fortschrittliche Behandlung, die ständig weiterentwickelt wird. In Zukunft werden wahrscheinlich neue Verfahren und Technologien entwickelt, die die Erfolgsraten verbessern und die Kosten senken.
Häufig gestellte Fragen
Wie hoch ist die Erfolgsrate von IVF?
Die Erfolgsrate von IVF hängt von verschiedenen Faktoren ab, wie z.B. Dem Alter der Frau, der Ursache der Unfruchtbarkeit und der Anzahl der übertragenen Embryonen. Im Durchschnitt liegt die Erfolgsrate bei etwa 30% pro IVF-Zyklus.
Wie viele IVF-Zyklen sind empfehlenswert?
Es gibt keine allgemeingültige Empfehlung für die Anzahl der IVF-Zyklen. Die Entscheidung, wie viele Zyklen durchgeführt werden sollen, hängt von den individuellen Umständen des Paares ab. In Deutschland werden die Kosten für maximal drei IVF-Zyklen von den Krankenkassen übernommen.
Gibt es eine Altersgrenze für IVF?
Es gibt keine gesetzliche Altersgrenze für IVF. Allerdings sinkt die Erfolgsrate von IVF mit zunehmendem Alter der Frau. Die meisten Kliniken bieten IVF-Behandlungen bis zu einem Alter von 45 Jahren an.
Wie lange dauert eine IVF-Behandlung?
Eine IVF-Behandlung dauert in der Regel mehrere Wochen. Der genaue Zeitaufwand hängt von den individuellen Umständen des Paares ab. Die Behandlung umfasst mehrere Termine bei der Klinik, die Durchführung von Bluttests und Ultraschalluntersuchungen sowie die Entnahme von Eizellen und Sperma.
Was sind die Risiken von IVF?
IVF birgt einige Risiken, die sowohl die Frau als auch den Embryo betreffen können. Zu den Risiken gehören Mehrlingsschwangerschaften, Überstimulation der Eierstöcke, Eileiterschwangerschaft, Fehlgeburt und Geburtsfehler.
Wie hoch sind die Kosten für eine IVF-Behandlung?
Die Kosten für eine IVF-Behandlung variieren je nach Klinik, Verfahren und Anzahl der Behandlungszyklen. In Deutschland liegen die Kosten für einen IVF-Zyklus zwischen 000 und 000 Euro. Die Kosten können durch zusätzliche Leistungen wie genetische Untersuchungen oder Einfrierung von Embryonen noch steigen.
Welche Voraussetzungen müssen erfüllt sein, um eine IVF-Behandlung zu erhalten?
In Deutschland ist IVF legal und wird von den Krankenkassen unter bestimmten Voraussetzungen bezuschusst. Die gesetzlichen Krankenkassen übernehmen in der Regel die Kosten für maximal drei IVF-Zyklen. Allerdings gibt es einige Einschränkungen, z.B. In Bezug auf das Alter der Frau und die Ursache der Unfruchtbarkeit.
Fazit
IVF ist eine komplexe und zeitaufwendige Behandlung, die jedoch vielen Paaren geholfen hat, ihren Traum von einem Kind zu verwirklichen. Die Entscheidung, ob eine IVF-Behandlung in Frage kommt, sollte mit dem Arzt besprochen werden. Der Arzt kann die individuellen Umstände des Paares beurteilen und eine fundierte Empfehlung geben.
Wenn Sie andere Artikel kennenlernen möchten, die Ivf: alles zur künstlichen befruchtung ähneln, können Sie die Kategorie Künstliche befruchtung besuchen.
